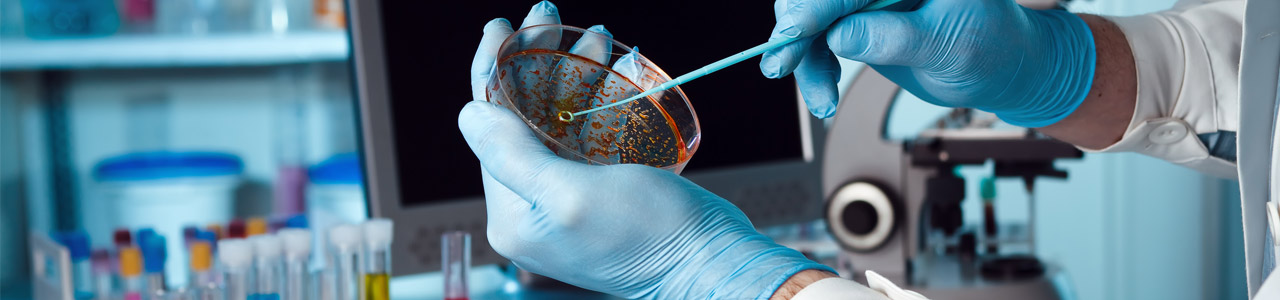

Kontakt
Dr. Möller & Schmelz GmbH
Robert-Bosch-Breite 15
D-37079 Göttingen
Deutschland
Tel. +49 551 66708
Fax +49 551 68895
info[at]moeller-schmelz.de
Geschäftsführer:
Michael Sawatzki
Dr. Otfried Möller